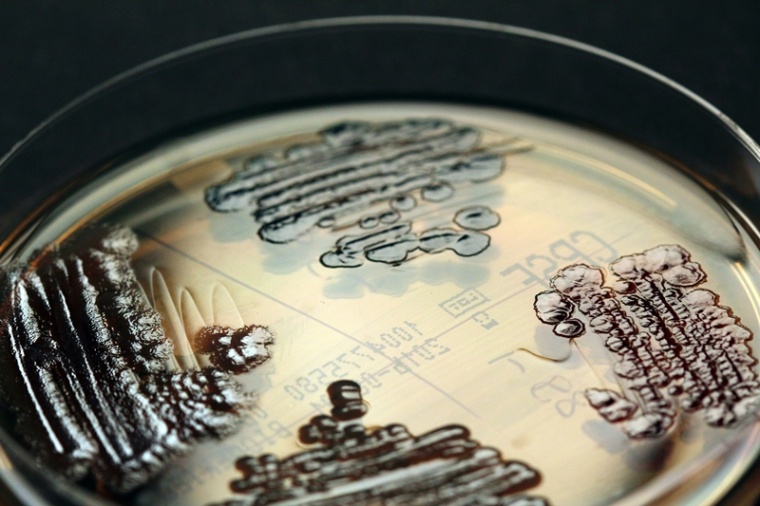
Multiresistente Enterobakterien in der Petrischale Foto: IMMIH, Köln/Hamprecht

Wie kommen die multiresistenten Bakterien ins Krankenhaus?
In Deutschland sterben bis zu 15.000 Patienten im Jahr an Krankenhausinfektionen, so schätzt das Nationale Referenzzentrum für die Überwachung dieser Infektionen.
Eine große Rolle spielen hier die multiresistenten Bakterien, denen die gängigen Antibiotika nichts mehr anhaben können. Doch wo kommen diese Keime her? Dieser Frage gingen DZIF-Wissenschaftler von der Uniklinik Köln nach und fanden in einer der bisher größten Studien dieser Art in Europa heraus, dass fast zehn Prozent der aufgenommenen Krankenhauspatienten die gefürchteten Keime bereits von zu Hause mitbringen.
„Dass fast jeder zehnte Patient mit multiresistenten Keimen besiedelt ist, wenn er in der Klinik ankommt, war für uns überraschend“, erklärt Dr. Axel Hamprecht von der Uniklinik Köln. Er und Prof. Harald Seifert, ebenfalls Uniklinik Köln, hatten zusammen mit Kollegen aus der Charité Berlin diese Studie koordiniert, an der sich sechs deutsche Universitätskliniken beteiligten. Über 4000 Erwachsene wurden bei Klinikaufnahme anhand von Stuhlproben oder Rektalabstrichen auf multiresistente Enterobakterien untersucht.
Enterobakterien wie Escherichia coli sind Bestandteil der normalen Darmflora und haben – so lange sie auf den Darm beschränkt sind – keinen Krankheitswert. Sie können jedoch Infektionen in anderen Organen hervorrufen wie zum Beispiel eine Harnwegsinfektion. Wenn eine Infektion durch multiresistente Bakterien hervorgerufen wird, ist diese sehr viel schwieriger zu therapieren und erfordert den Einsatz von Reserveantibiotika. Besonderes Augenmerk legten die Forscher in ihrer Untersuchung auf eine Gruppe von multiresistenten Bakterien, die häufig in Krankenhäusern Probleme bereiten: die sog. 3. Generations-Cephalosporin-resistenten Enterobakterien (3GCREB).
Diese multiresistenten Darmbakterien, die unter anderem gegen Cephalosporine resistent sind, haben sich in den vergangenen Jahren weltweit ausgebreitet. Cephalosporine sind Antibiotika, die ähnlich wie das Penicillin den Aufbau der bakteriellen Zellwand hemmen und die Bakterien auf diese Weise töten. Die neueren Cephalosporine der dritten Generation wirken gegen ein breites Spektrum an Bakterien und gehören zu den am häufigsten eingesetzten Antibiotika. Doch die Bakterien setzen sich zur Wehr und haben im Laufe der Zeit ein Enzym erworben, die Beta-Laktamase, das diese Antibiotika unwirksam macht. Enterobakterien werden durch Schmierinfektion, meistens über Fäkalien oder über Lebensmittel, übertragen.
Jeder zehnte Patient bringt die Keime mit ins Krankenhaus
Von den 4376 Erwachsenen, die bei Aufnahme in eine der beteiligten Kliniken auf die 3GCREB-Keime untersucht wurden, waren 416 Träger dieser multiresistenten Keime. Diese Häufigkeit war bisher in Deutschland nicht bekannt. Besonders häufig fanden die Wissen-schaftler Escherichia coli-Bakterien, die Beta-Laktamasen produzieren, sog. ESBL-Enterobakterien. Die Häufigkeit der multiresistenten Keime war von Klinik zu Klinik unterschiedlich.
Um ursächliche Faktoren für die Besiedelung mit diesen Bakterien aufzudecken, beantworteten die Patienten ergänzend einen Fragenkatalog zu bisherigen Klinikaufenthalten oder Lebensgewohnheiten. „Patienten nach Antibiotika-Einnahme und Reisende außerhalb Europas sind gefährdeter“, nennt Hamprecht zwei wichtige Ergebnisse der Recherchen.
Experten raten zu mehr Hygiene und weniger Antibiotika
Was kann getan werden, um die multiresistenten Keime möglichst frühzeitig aufzuhalten? „Bei so vielen Betroffenen funktioniert die Strategie einer Isolation innerhalb des Krankenhauses nicht mehr“, ist sich Hamprecht sicher. Zudem gebe es bei 3GCREB im Gegensatz zu anderen multiresistenten Bakteriengruppen wie MRSA (Methicillin-resistente Staphylococcus-aureus)-Stämme keine etablierten Sanierungsmöglichkeiten.“ Stattdessen empfehlen Hamprecht und Seifert bessere Hygienemaßnahmen in Kliniken und Praxen, einen rationalen Umgang mit Antibiotika sowie insbesondere eine Reduktion nicht gerechtfertigter Antibiotika-Gaben und mehr Schulungen für Ärzte.
Die Studie wurde im Rahmen der Antibiotika-Therapie-Optimierungs-Studie (ATHOS) durchgeführt. Weitere beteiligte Zentren sind die Charité Universitätsmedizin Berlin sowie die Unikliniken in Freiburg, Lübeck, München und Tübingen.
Anbieter












